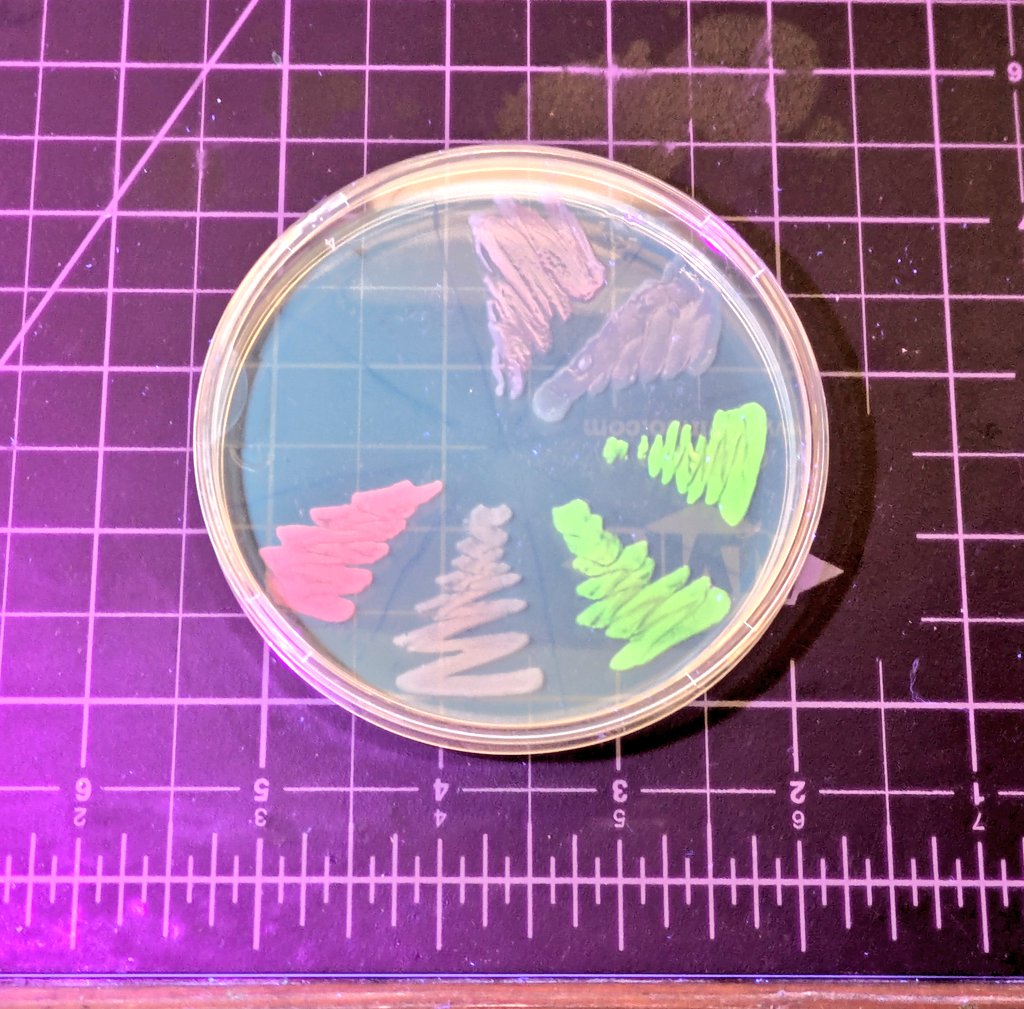
Media 1

Your curated collection of saved posts and media
GuysโฆI have a girlfriend. Now I know what youโre thinkingโฆhow is it possible that anyone would want to be with me? I understand where youโre coming from. I think the answer is: her puzzle piece fits mine. In my early twenties, I read the biography of the American founding father John Adams. He and his wife Abigail had one of the great partnerships in American history; intellectually matched, emotionally intertwined, and co-architects of something bigger than themselves. I wanted what they had. But it wasnโt within reach. Years before, Iโd married in a sort of arranged Mormon marriage. Unsure how else to explain it. We were functional, but we werenโt John and Abigail. We split after thirteen years. At age 34, after selling Braintree Venmo, and emerging from a mismatched marriage and the repression of Mormonism, I set out to rebuild myself and find partnership.ย I met a woman in LA who became my first-ever girlfriend. Coming from a sheltered background, I was blind to the obvious warnings. I was dangerously naive. That relationship unraveled and was followed by litigation. The experience was unnerving and left me wondering if I could ever trust again. By the time I was 44, I started reconciling with the possibility of a life without partnership. @_katetolo and I met at my brain interface company Kernel. Sheโd discovered my work using neurotechnology to improve human well-being and merge human and AI. Even though sheโd been dreaming of a career in fashion, she was drawn to what she foresaw as the defining question of our time: how will humans successfully co-evolve with AI. We shared the same obsession. The puzzle piece fit was immediate, as immediate as either of us had ever experienced. Yet we maintained our professional boundaries. When we worked on our first project together, the back and forth was effortless. She could conceptualize and feel what I couldnโt and vice versa. It helped that both Kate and I had a natural disposition towards hard work. Our joy came from creation. Kate was luminescent. When I saw her about the office, butterflies fluttered in my stomach.ย Each day sheโd show up wearing some unexpected combination of colors, textures, styles and accessories. Always tasteful, playful and interesting. She didnโt chase fancy brands. Most of her clothing was from the thrift store. It wasnโt how she looked but how her mind worked: original, eccentric, entirely her own. She was art. We both worked very hard and valued every second of the day.ย One evening around 6:30 pm she dropped by my office and we talked for hours. It had been all business before.ย This was the first time we stepped into each otherโs personal lives. My heart strings pulled but my brain pushed back. โWe know we canโt trust againโ, my mind firmly stated. Our after-hours meet-ups in my office became a daily ritual. The favorite part of my day. Weโd reminisce about work and tiptoe a bit deeper each time into each otherโs personal lives. Iโd recently started my new anti-aging project and one night Kate suggested to me that I should put the entire thing online to allow others to follow on. We worked together to put up a website and got a v1 out. We pondered what to call it, and decided on โProject Blueprintโ. We were oddly from entirely different worlds but somehow the same person. Yet neither of us dared take the next step. We didnโt want to imperil our work relationship and we remained deeply skeptical of each other.ย The combination of Kate being raised to distrust all things and me still feeling the sting of the previous relationship left us stirring in a pot of anticipatory disaster. Before long, whether we liked it or not, weโd become each other's favorite person. Weโd spend every moment we could together. Social events and the weekends were still off-limits as our relationship was professional. We were both secretly wondering, โdoes the other person feel what Iโm feeling?โ Unable to withstand any longer, after a year and a half of unspoken affection, one night I softly floated the balloon of inquiry. She confirmed it was reciprocal. Still, with things being so new, neither of us wanted to make our relationship public. We needed time to stabilize, mature and assess whether this was short or long term. Iโm a 48 year old American, raised Mormon, with three children. Sheโs a 30 year old Bosnian-Australian-American. It took time to bridge our worlds. In our years of knowing each other, three of them have been navigating a relationship. All while building a business and movement. There have been many times where we didnโt know if weโd make it. In the last year, weโve found our flow.ย I trust Kate as much as my mother. She knows how to scaffold trust. She anticipates your anticipation and knows your reaction before you react. Sheโs meticulous in the integrity of our relationship. Sheโs even been pivotal in helping my father and me reconcile and navigate the contours of our relationship. In the past few years, Blueprint and Donโt Die have become global phenomena. Kate is the unsung hero.ย She and I have been stride on stride since inception. Sheโs proven an exceptional executor and despite her unconventional background, intuitively knows things. Her creativity keeps me forever guessing what sheโll say or come up with next. Our minds have become so intertwined that life feels naked without her. Her story warrants being told as others will be better off emulating her practices and abilities. What I find most impressive about Kate is her prescience and thoughtfulness. She sees forwards, backwards, and side to side. Relative to her, I feel myopic in my awareness of the world. She can see through others, as an x-ray would. She then structures all that information and can package it in simple, understandable terms. In ways that allow for everyone to win. Kate is soft spoken, self-deprecating and understated. These attributes cloak her ferocious ambition, piercing intellect, and delightful creativity. Give her five minutes and she will reframe your world. But most people donโt know to look. They assume sheโs my assistant. Itโs such a loss because people are looking for what she has to offer. My son Talmage, Kate, and I are family. Nothing makes us happier than being together. Our conversations are fast, dark, and rowdy. Family feeds the soul, and we are nourished. As my son considers possible partners, he wisely models them off of Kate. Deep companionship is a universal human want.ย And while there are eight billion of us on this planet, most struggle to achieve it, including those in relationships. Itโs the most fulfilling of human experiences and also the most elusive. The joy of being seen, appreciated and loved, and offering the same to another. I wrote dozens of different sentences trying to capture what the want and struggle for deep companionship feels like. I deleted them all as none could holistically capture the emotional architecture of it. Then one day while exercising, I realized what it feels like: what the explorer Ernest Shackleton and his crew must have felt returning to land after being shipwrecked and surviving 497 days adrift in brutal Antarctic. Itโs a bit of a dramatic comparison, however, I suspect many of you can relate. Kate feels like land to me after being adrift and searching for 25 years. Life sinks or sails based upon the quality of our most intimate relationships. No amount of professional success can plug the sinking hole of an acrimonious personal relationship. At this point, Kate and I have nearly become one person. We have entire conversations with a single look, sound, gesture or image. We independently come up with the same ideas and insights, suggesting to me that maybe itโs our tandem effort generating them. Our relationship is stable, positive, and calm. Iโve wanted this my entire life and impatiently waited 25 years for it to arrive. Itโs better than anything I imagined. Lucky me, I found my Abigail Adams.
@hypersoren Agree, seat revenue became irrelevant when companies did mass layoffs in 2022. Metronome has great frameworks and proof points on pricing for AI. https://t.co/GcyIGSl739
Replit left San Francisco for Foster City. The "why" we're leaving is boring, sad, and predictable (crime, dysfunction, etc), so instead let me tell you why we chose Foster City. Foster City embodies the American post-war optimism and the long-lost California pro-growth mentality. in 1958 businessman Jack Foster set out to build "a master-planned community concept"; in 1960 bought Brewer Island, a largely undeveloped land used for salt evaporation and dairy farming; in 1961 started building, and in 1964, the first family moved in. By 1966, more than 5,000 people were living there. Can you imagine how long it would take to build such a project today? The city is also known for its innovative engineering, particularly its "Venice-like" lagoon system. Instead of employing massive landfills to elevate the terrain for development, engineers devised a system of lagoons that provided essential drainage and a super cool aesthetic landscape. Finally, the city is super livable. When Haya and I moved to California, we first took residence there and, in fact, incorporated Replit here. Our first bank was Wells Fargo, a few steps from our new office. It's relatively affordable compared to the rest of the Bay Area and has a healthy mix of residential, commercial, and recreational spaces. Downtown San Mateo is a bridge away, a fun place to hang out or live. Finally, in the Bay Area, almost every town has an associated iconic tech company. When you think of Mountain View, you think of Google; when you think of Cupertino, you think of Apple. My hope is that in the future, when you think of Foster City, you'll think of Replit.

Haters will say the Bay Area doesnโt have seasons without ever going to Foster City https://t.co/caCa7x4aIa
Replit left San Francisco for Foster City. The "why" we're leaving is boring, sad, and predictable (crime, dysfunction, etc), so instead let me tell you why we chose Foster City. Foster City embodies the American post-war optimism and the long-lost California pro-growth mentali
Just found Handy โ Free Fast Speech-To-Text that actually runs on your local machine: ๐ค Hit a shortcut (Ctrl+Space), speak, get text. That's it. ๐ Zero cloud processing. Your audio never leaves your computer. ๐ Free, open source, works on Windows/macOS/Linux https://t.co/JRlrhWBYin
โก Uses Whisper/Parakeet models locally (GPU accelerated when available) Rare to see accessibility tools that don't eventually hide behind paywalls. Worth checking out if you care about local-first software. https://t.co/zQmvcZze6z
Meetย Glow: a beautiful Markdown reader for your terminal. @charmcli โจ Read docs in style ๐ Find local & Git-based files โก๏ธ See the power of the CLI https://t.co/7cWEYYl1f1
https://t.co/20XxcObShX
@pcuenq It didn't get better with the 5090.... I had to find another reason other than my bday... ๐ https://t.co/f12qP4LrDB
Monospaced font for developers with low vision https://t.co/XF0MaEiLSg https://t.co/SbVooHB4mN
Monospaced font for developers with low vision https://t.co/XF0MaEiLSg https://t.co/SbVooHB4mN

Gaussians on Fire: High-Frequency Reconstruction of Flames Contributions: 1. We introduce Gaussians on Fire, a complete pipeline for reconstructing spatio-temporal flame dynamics from only three synchronized cameras. 2. We propose a flow-initialized dynamic Gaussian representation, where dense optical flow fields are fused across views to form an initial 3D flow volume that drives Gaussian motion initialization. 3. We construct and evaluate a real-world dataset of fire sequences captured with a hardware-synchronized three-camera rig and present quantitative and qualitative experiments demonstrating that our approach produces temporally coherent, high-frequency reconstructions of flame dynamics under sparse capture conditions. 4. We define a capturing setup that only requires three cameras and a hardware synchronization pattern that allows us to utilize rolling shutter artifacts for microsecond-level synchronization of the cameras.

What if AI video generation could be as fast as hitting "play"? Use Self-Forcing to turn Wan 2.1 as a real-time video generator. 12-15 fps on a 5090... Code for demo application can be found here. https://t.co/3teO8SzBqF https://t.co/nAazEB3Uwz
Dataset for consistent identity preservation in image editing https://t.co/JkSzYcK47R https://t.co/xAycBiljrU

Dataset for consistent identity preservation in image editing https://t.co/JkSzYcK47R https://t.co/xAycBiljrU

Glance Accelerating Diffusion Models with 1 Sample https://t.co/1BGlRCpEc8
Glance Accelerating Diffusion Models with 1 Sample https://t.co/1BGlRCpEc8
Mark Sharp: well done wysiwyg markdown editor for vscode. https://t.co/T7BiDcT1jm
A new era of physics-aware video generation is here! Introducing NewtonRewards, a framework that enforces Newton's Laws in video diffusion models. It achieves physically plausible, smooth, and temporally coherent motions through verifiable rewards, outperforming prior methods. https://t.co/2Y1upObMvD
Just to calibrate, tech unicorn founders are much rarer than pro athletes. https://t.co/Fauk5QXhYA
Just to calibrate, tech unicorn founders are much rarer than pro athletes. https://t.co/Fauk5QXhYA
@JeffDean :( https://t.co/Gq92yduzWP
Putting some bacteria in marmite broth between an LED and a phototransistor, you can see the lag, then rapid exponential growth, then tapering off as it runs out of oxygen/nutrients. Fun to see a textbook chart re-created with parts I had lying around :) https://t.co/kV0zWLEL9j

Lux genes have been achieved internally ๐ https://t.co/ibS6iaBAAQ

This video by @jbhuang0604 manages to cram in all the core pieces of modern attention variants, a perfect refresher if you (like me) need a reminder of the differences between MHA, GQA, MLA, DSA etc :) https://t.co/UrjLHvn1v2 https://t.co/kWlKtfTYkN

I need to give some background on LeJEPA and SIGReg for a class today, and I figured it was a good excuse to try Kimi slides with ๐. Not perfect of course but dang!! Next step: hook ๐ up to something watching me speak and auto-generating slides in the background in real time. https://t.co/pA1dZH5zAX
A day later at room temp. Writeup: https://t.co/G5pLRs8Mcj https://t.co/hqj94buka4
Got myself some of @ATinyGreenCell's colorful creations ๐๐๐ Hopefully I can add more colors to the collection over time! (https://t.co/BF6L0xP0x5 if you want to support a cool scientist) https://t.co/5rQIRW27BK
Qwen just won Best Paper Award at NeurIPS. And it wasnโt for a flashy new architecture. It was for fixing a problem Transformers had for years. Hereโs what you need to know: https://t.co/6L3Wnxs4xs
In my latest newsletter (free), a sprite gif animator library (I made) to get a gif from your Nano Banana Pro sprites, plus a look at Midjourney style creator beta .... 1/3 https://t.co/vIX6ABcsm8
Making a folk horror style in @midjourney, some steps in it's evolution 2/3 https://t.co/MJvdSNTUhG
This is a super interesting paper on multi-agents for code patching. Claims SOTA on the SWE-bench Verified leaderboard (79.4%). Why this matters: Automated bug fixing is improving fast. But there's a catch. Patches that pass existing tests often fail on edge cases. The tests weren't designed to stress the fix. The fix wasn't designed to handle unusual inputs. Both are developed in isolation. This creates fragile patches that work in testing but break in production. This new research introduces InfCode, a framework where tests and patches challenge each other through adversarial iteration. The key idea: treat test generation and patch creation as opposing forces. Tests try to break patches. Patches evolve to survive. Both get stronger through conflict. The framework operates in cycles. Generate tests designed to expose patch weaknesses. Refine patches to handle those failures. Generate harder tests. Repeat until the patch is robust. What makes this powerful: patches earn their reliability. They don't just pass tests designed before the fix existed. They survive tests specifically crafted to break them. Evaluated on SWE-Bench Verified, the approach shows measurable gains in patch quality and coverage. Leads to fewer regressions and more robust fixes. Paper: https://t.co/DvAIxIKiPK